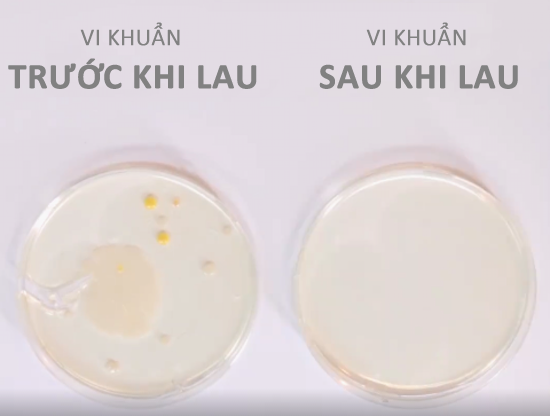
Điện thoại bẩn hơn toilet 10 lần, đ&acirc;y l&agrave; c&aacute;ch đơn giản lại hiệu quả để lau ch&ugrave;i - Ảnh 4.

Ai cũng cho rằng toilet rất bẩn và chứa đầy vi khuẩn. Tuy nhiên, có một sự thật "giật mình" mà khoa học đã chứng minh là số vi khuẩn trên chiếc smartphone mà bạn mang theo mỗi ngày thậm chí còn bẩn hơi toilet gấp... 10 lần. Một trong những lí do giải thích cho điều này đến từ việc nhiều người dùng chưa hình thành thói quen lau chùi điện thoại thường xuyên hoặc cách lau chùi chưa hiệu quả. Nếu bạn nằm trong số này, nội dung bên dưới sẽ mang đến cho bạn một gợi ý đơn giản nhưng vô cùng hữu hiệu.
Vật dụng cần thiết:
- Nước đóng chai
- Cồn isopisopropyl nồng độ 70%
- Một bình xịt nhỏ
- Miếng lau kính (sợi tổng hợp hoặc loại vải không bỏ sót sợi)
Điện thoại được xếp vào nhóm các vật dụng hàng ngày... bẩn nhất.
Giờ thì cùng bắt đầu nào!
- Bước 1: Đổ nước đóng chai đầy một nửa chiếc bình xịt mà bạn đã chuẩn bị. Lý do bạn nên sử dụng nước đóng chai là bởi nó không chứa bất kì tạp chất nào có thể ảnh hưởng đến chất lượng hoặc làm xước màn hình.
- Bước 2: Đổ cồn isopisopropyl nồng độ 70% vào nửa bình xịt còn lại. Đây là loại cồn bạn có thể dễ dàng mua được ở các hiệu thuốc. Hãy chú ý đến nồng độ cồn bởi nồng độ 70% là vừa đủ để vừa làm sạch điện thoại vừa không ảnh hưởng đến chất lượng màn hình như nồng độ cao hơn như 91% hay 99%.
- Bước 3: Tiếp theo, hãy đóng nắp bình và lắc đều "hỗn hợp".
- Bước 4: Xịt "hỗn hợp" vừa tạo ra vào một chiếc khăn lau kính. Bạn đọc lưu ý tuyệt đối tránh xịt trực tiếp lên màn hình và cũng không cần thiết phải làm khăn quá ướt trước khi lau. Chỉ cần xịt từ một đến hai lần là đủ.
- Bước 5: Đến đây, tất cả những gì bạn cần làm là lau sạch sẽ "dế yêu" của mình, đặc biệt là phần các nút bấm. Điểm cộng cho "hỗn hợp" mà chúng ta vừa tạo ra là khả năng bay hơi nhanh chóng nên điện thoại khô rất nhanh.
Chú ý: với cách vệ sinh điện thoại này, bạn được khuyến cáo là không nên áp dụng quá một lần trên một tuần bởi lạm dụng nó có thể ảnh hưởng đến chất lượng các lớp phủ trên màn hình. Đối với việc lau chùi hàng ngày, sử dụng một miếng lau kính khô là đủ.
Đây là thành quả của công việc lau chùi!
Chúc các bạn thành công!
(Tham khảo: BuzzFeed)